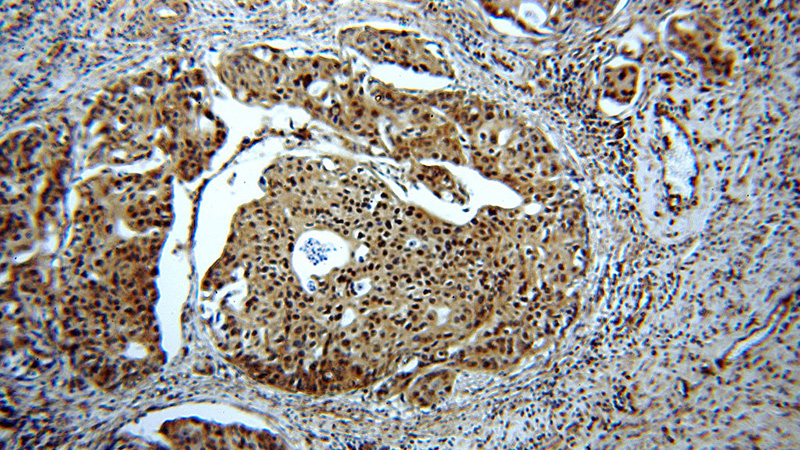
Immunohistochemical of paraffin-embedded human cervical cancer using Catalog No:109157(CDC2-Specific antibody) at dilution of 1:50 (under 10x lens)

-
Product Name
CDK1-Specific antibody
- Documents
-
Description
CDK1-Specific Rabbit Polyclonal antibody. Positive WB detected in HeLa cells, A431 cells, HEK-293 cells, MCF7 cells. Positive IP detected in HEK-293 cells. Positive IF detected in HeLa cells. Positive IHC detected in human cervical cancer tissue. Observed molecular weight by Western-blot: 34 kDa
-
Tested applications
ELISA, WB, IHC, IP, IF
-
Species reactivity
Human,Mouse,Rat; other species not tested.
-
Alternative names
CDC2 antibody; CDC28A antibody; CDK1 antibody; Cell division protein kinase 1 antibody; Cyclin dependent kinase 1 antibody; DKFZp686L20222 antibody; p34 protein kinase antibody
-
Isotype
Rabbit IgG
-
Preparation
This antibody was obtained by immunization of Peptide (Accession Number: NM_001786). Purification method: Antigen affinity purified.
-
Clonality
Polyclonal
-
Formulation
PBS with 0.02% sodium azide and 50% glycerol pH 7.3.
-
Storage instructions
Store at -20℃. DO NOT ALIQUOT
-
Applications
Recommended Dilution:
WB: 1:200-1:1000
IP: 1:200-1:1000
IHC: 1:20-1:200
IF: 1:20-1:200
-
Validations

HeLa cells were subjected to SDS PAGE followed by western blot with Catalog No:109157(CDC2-Specific antibody) at dilution of 1:100
Immunohistochemical of paraffin-embedded human cervical cancer using Catalog No:109157(CDC2-Specific antibody) at dilution of 1:50 (under 10x lens)

Immunohistochemical of paraffin-embedded human cervical cancer using Catalog No:109157(CDC2-Specific antibody) at dilution of 1:50 (under 40x lens)

IP Result of anti-CDC2-Specific (IP:Catalog No:109157, 4ug; Detection:Catalog No:109157 1:200) with HEK-293 cells lysate 2800ug.

Immunofluorescent analysis of HeLa cells using Catalog No:109157(CDC2-Specific Antibody) at dilution of 1:50 and Alexa Fluor 488-congugated AffiniPure Goat Anti-Rabbit IgG(H+L)
-
Background
CDK1, also named as CDC2, belongs to the protein kinase superfamily, CMGC Ser/Thr protein kinase family and CDC2/CDKX subfamily.CDC2 plays a key role in the control of the eukaryotic cell cycle. It is required in higher cells for entry into S-phase and mitosis. CDC2 is a catalytic subunit of the highly conserved protein kinase complex known as M-phase promoting factor (MPF), which is essential for G1/S and G2/M phase transitions of eukaryotic cell cycle. It is a component of the kinase complex that phosphorylates the repetitive C-terminus of RNA polymerase II. Mitotic cyclins stably associate with CDC2 and function as regulatory subunits. The antibody is specific to the 2 isoforms of CDC2.
-
References
- Zheng L, Wang X, Luo W, Zhan Y, Zhang Y. Brucine, an effective natural compound derived from nux-vomica, induces G1 phase arrest and apoptosis in LoVo cells. Food and chemical toxicology : an international journal published for the British Industrial Biological Research Association. 58:332-9. 2013.
- Sun S, Han Y, Liu J. Trichostatin A targets the mitochondrial respiratory chain, increasing mitochondrial reactive oxygen species production to trigger apoptosis in human breast cancer cells. PloS one. 9(3):e91610. 2014.
- Liu Z, Yang L, Teng X, Zhang H, Guan H. The involvement of CXCR7 in modulating the progression of papillary thyroid carcinoma. The Journal of surgical research. 191(2):379-88. 2014.
- Dai B, Zhan Y, Qi J, Zhang Y. Eupolyphaga sinensis Walker inhibits human chronic myeloid leukemia cell K562 growth by inducing G2-M phase cell cycle arrest and targeting EGFR signaling pathway and in S180 tumor-bearing mice. Environmental toxicology and pharmacology. 37(3):1177-85. 2014.
- Zhang Y, Zhan Y, Zhang D. Eupolyphaga sinensis walker displays inhibition on hepatocellular carcinoma through regulating cell growth and metastasis signaling. Scientific reports. 4:5518. 2014.
- Wang Z, Xu D, Gao Y. Immature Colon Carcinoma Transcript 1 Is Essential for Prostate Cancer Cell Viability and Proliferation. Cancer biotherapy & radiopharmaceuticals. 30(7):278-84. 2015.
- He Y, Cao X, Liu X. Quercetin reverses experimental pulmonary arterial hypertension by modulating the TrkA pathway. Experimental cell research. 339(1):122-34. 2015.
- Zhan W, Han T, Zhang C. TRIM59 Promotes the Proliferation and Migration of Non-Small Cell Lung Cancer Cells by Upregulating Cell Cycle Related Proteins. PloS one. 10(11):e0142596. 2015.
Related Products / Services
Please note: All products are "FOR RESEARCH USE ONLY AND ARE NOT INTENDED FOR DIAGNOSTIC OR THERAPEUTIC USE"
